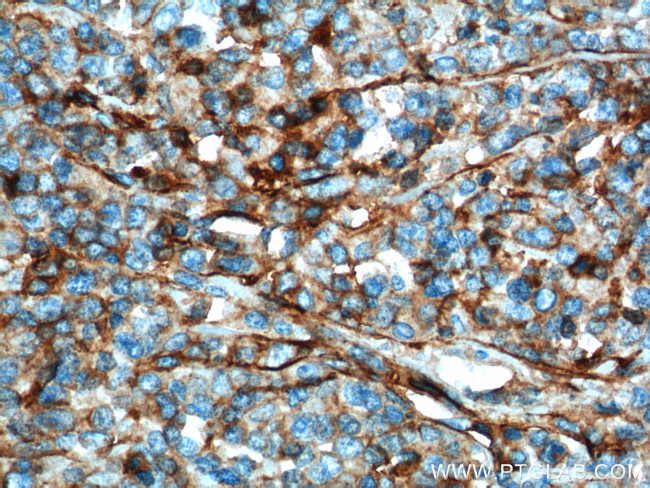
IFITM1 Antibody in Immunohistochemistry (Paraffin) (IHC (P))

Search
Proteintech
IFITM1 Monoclonal Antibody (5B5E2)
{{$productOrderCtrl.translations['antibody.pdp.commerceCard.promotion.promotions']}}
{{$productOrderCtrl.translations['antibody.pdp.commerceCard.promotion.viewpromo']}}
{{$productOrderCtrl.translations['antibody.pdp.commerceCard.promotion.promocode']}}: {{promo.promoCode}} {{promo.promoTitle}} {{promo.promoDescription}}. {{$productOrderCtrl.translations['antibody.pdp.commerceCard.promotion.learnmore']}}
产品信息
60074-1-IG
种属反应
已发表种属
宿主/亚型
分类
类型
克隆号
抗原
偶联物
形式
浓度
规格
纯化类型
保存液
内含物
保存条件
运输条件
产品详细信息
60074-1-Ig is a mouse monoclonal antibody which specifically recognizes IFITM1 but not IFITM2 or IFITM3.
Immunogen sequence: MHKEEHEVA VLGAPPSTIL PRSTVINIHS ETSVPDHVVW SLFNTLFLNW CCLGFIAFAY SVKSRDRKMV GDVTGAQAYA STAKCLNIWA LILGILMTIG FILLLVFGSV TVYHIMLQII QEKRGY (1-125 aa encoded by B C000897)
靶标信息
IFITM1 (Interferon inducible transmembrane protein 1) is a member of the IFN-inducible transmembrane protein family. It is an essential mediator of interferon-gamma-induced antiproliferation and plays a role in the control of cell growth. IFITM1 is upregulated in several tumor types and may be useful as a tumor biomarker. Both mouse IFITM1 and IFITM3 are expressed on the cell surfaces of primordial germ cells in a developmentally-regulated manner. IFITM1 activity is required for primordial germ cell transit, and IFITM1 acts as a repulsive molecule by repelling non-IFITM1-expressing primordial germ cells from the mesoderm into the endoderm.
仅用于科研。不用于诊断过程。未经明确授权不得转售。
生物信息学
蛋白别名: 27-Sep; CD225; Dispanin subfamily A member 2a; DSPA2a; Interferon-induced protein 17; Interferon-induced transmembrane protein 1; Interferon-inducible protein 9-27; Leu-13 antigen; unnamed protein product
基因别名: 9-27; CD225; DSPA2a; IFI17; IFITM1; LEU13
UniProt ID: (Human) P13164
Entrez Gene ID: (Human) 8519